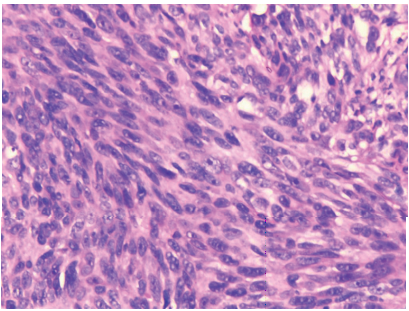

眼睑无色素性黑色素瘤伪装成霰粒肿1例
阅读量:1907
DOI: doi: 10.3978/j.issn.1000-4432.2017.03.02
发布日期:2024-12-29
作者:
陈丽红 ,林健贤 ,李永平 ,张文忻 ,毛羽翔 ,高欢欢 ,唐丽娟 ,张平
展开更多 '%20fill='white'%20fill-opacity='0.01'/%3e%3cmask%20id='mask0_3477_29692'%20style='mask-type:luminance'%20maskUnits='userSpaceOnUse'%20x='0'%20y='0'%20width='16'%20height='16'%3e%3crect%20id='&%23232;&%23146;&%23153;&%23231;&%23137;&%23136;_2'%20x='16'%20width='16'%20height='16'%20transform='rotate(90%2016%200)'%20fill='white'/%3e%3c/mask%3e%3cg%20mask='url(%23mask0_3477_29692)'%3e%3cpath%20id='&%23232;&%23183;&%23175;&%23229;&%23190;&%23132;'%20d='M14%205L8%2011L2%205'%20stroke='%23333333'%20stroke-width='1.5'%20stroke-linecap='round'%20stroke-linejoin='round'/%3e%3c/g%3e%3c/g%3e%3c/svg%3e)
关键词
睑结膜
无色素性黑色素瘤
病理
摘要
报道一例发生在41岁中年女性左眼上睑的无色素性黑色素瘤,曾在当地医院误诊为霰粒肿。体检见左眼上睑结膜面一大小约2 cm × 2 cm红色肿物,手术切除肿物送病理检查,标本经10%福尔马林固定,常规石蜡包埋切片,HE染色及免疫组织化学染色。光镜下见肿瘤细胞呈片状及巢状排列,瘤细胞圆形及梭形,部分瘤细胞胞浆空泡状呈气球样形,部分细胞核仁明显。免疫组化显示肿瘤细胞S-100、HMB-45阳性,CK及EMA阴性,最终病理诊断为左眼上睑无色素性黑色素瘤。对于临床上患者年龄较大无典型霰粒肿特征的眼睑肿物,术后标本均应送病理检查以除外其它肿瘤的可能。
全文
1 病例资料
患者,女,41岁。半年前无明显诱因发现左眼上睑肿物一周,在当地医院诊断为“霰粒肿”,分别于6月前、3月余前两次行“左眼霰粒肿刮除术”,未做病理检查。患者术后仍觉左眼异物感,上睑进行性肿胀,于2015年9月6日到我院进一步诊治。体检:左眼上睑结膜面见一大小约2 cm × 2 cm隆起肿物,边界欠清,色红,无溃烂及出血,无明显压痛(图1),其余眼部专科检查及全身检查未见明显异常,一般状况好。临床诊断为左眼眼睑肿物(可疑睑板腺癌)。患者经局部麻醉,行“左眼眼睑
肿物切除术”,术中完整切除红色肿物,送病理检查。标本经10%福尔马林固定,常规石蜡包埋切片,HE染色。光镜下见部分瘤细胞小片状及巢状排列,细胞呈圆形或多边形,部分瘤细胞呈胞浆空泡状的气球样细胞(图2),边界清楚,胞浆中等,核大,核仁明显。部分肿瘤细胞呈梭形,交错排列,核梭形或卵圆形(图3)。免疫组化S-100(+)、HMB45(+)、CK(−) (图4)、Vimentin(+)、EMA(−)、Ki-67阳性指数约40%。病理诊断为左眼上睑无色素性黑色素瘤,切缘未见肿瘤细胞。术后随访1年余,未见肿瘤复发。





图1 临床检查发现左眼上睑结膜面肿物,边界欠清,色红,无溃烂及出血
Figure 1 Physical examination revealed an unclear boundary
reddish tumor in the palpebral conjunctiva of leff upper eyelid
without ulceration and bleeding

图2 部分瘤细胞呈巢状排列,细胞圆形、椭圆形,胞浆空
泡状HE染色 ×200
Figure 2 Partial tumor cells were round and oval with
vacuolated cytoplasm and in nest arrangement (H &E stain,×200)
图3 部分瘤细胞呈梭形,交错排列,核梭形或卵圆形HE染色 ×200
Figure 3 Partial tumor cells were spindle-shaped with round
or oval nucleus and in interlaced arrangement (H &E stain,×200)

图4 肿瘤细胞HMB-45 (A, ×200)及S100 (B, ×200)表达阳性; CK表达阴性(C, ×200);Ki-67阳性指数约40% (D, ×200)免疫
组织化学染色
Figure 4 TTe tumor cells were positive for HMB-45 (A, ×200) and S100(B, ×200 ), negative for cytokeratin (C, ×200); TTe tumor
cells were 40% positive for Ki-67 (D, ×200) (IHC stain)
2 讨论
眼睑黑色素瘤是一种高度恶性的黑色素细胞来源的肿瘤,占眼睑恶性肿瘤不到5%[1],眼睑无色素性黑色素瘤则更少见[2], 具有局部容易复发、多发生耳前淋巴或颌下淋巴结转移的特点[3]。眼睑黑色素瘤半数以上发生在睑缘部,上睑多于下睑[4],
好发于40至60岁中老年人,70至80岁老年人为高发年龄段,在年龄低于60岁病人中的发病率逐渐增加[5],但无明显性别差异[6]。本例患者41岁,属于黑色素瘤好发年龄。但本例病变发生在上睑结膜面,而且没有色素,比较罕见,也容易误诊。
眼睑黑色素瘤在临床上常常表现为睑结膜面边界不规则的结节状隆起肿物,黑色素瘤的典型临床特点表现为ABCD法则,即肿物形状的不
对称性(Asymmetry),边界的不规则性(Border),
颜色的不均匀性 (Colour),及直径大于5 mm
(Diameter)。但眼睑无色素性的黑色素瘤早期体积小时常常表现为睑结膜面一近圆形或椭圆形小结节,色红,易与霰粒肿相混淆。其鉴别点在于:1)发病年龄不同,眼睑无色素性黑色素瘤多发生于40至60岁中老年人,而霰粒肿好发于青少年,皮脂腺分泌功能旺盛时期[7]。2)眼睑无色素性黑色素瘤一般为鲜红色,而霰粒肿常呈紫红色。3)无色素性黑色素瘤一般边界不规则、外形不对称,而霰粒肿一般为边界规则的圆形或椭圆形肿物。本例患者病变发生于上睑结膜面,因为没有色素,病变呈红色,所以容易误诊为霰粒肿,但本
例患者41岁,不属于霰粒肿的好发年龄,所以临床上遇到年龄较大的发生于睑板的病变,应考虑睑板腺癌、无色素性黑色素瘤等病变的可能,切除的标本应送病理检查。
黑色素瘤组织学及细胞形态表现多样[8],叶明福等[9]根据130例黑色素瘤光镜下的瘤细胞组织及形态特征归纳总结出14种不同的组织学类型。主要有: 1)上皮样型瘤组织呈片巢状、梁索状以及弥漫上皮样排列,瘤细胞圆形、椭圆形;2)肉瘤样型瘤细胞呈束状、漩涡状或弥漫肉瘤样排列,以大小不等,形态不一的梭形细胞为主;3)小细胞型瘤细胞多呈弥漫分布,瘤细胞圆形,体积小,胞质极少,其形态非常类似于恶性淋巴瘤、小细胞癌或其他小细胞恶性肿瘤;4)瘤细胞多呈裂隙状或腔隙样,腔内无分泌物,是此型黑瘤特有的结构;5)浆细胞样型单个瘤细胞呈弥散或密集分布,多为单一的浆细胞样细胞,其形态与浆细胞肉瘤非常相似。除外主要的组织学类型,还包括透明细胞型、横纹肌样型、巨细胞
型、印戒细胞型、气球样细胞型及炎性MFH样型等罕见类型。当瘤组织中无色素或少色素时,上皮样型极易误认为癌,肉瘤样型易与其他类型的软组织肉瘤相混淆,无色素性小细胞型黑色素瘤需与小细胞恶性肿瘤鉴别,假腺样型较难与腺癌或其他腺泡状软组织肿瘤区别,浆细胞样型类似于浆细胞肉瘤,透明细胞型黑色素瘤与透明细胞癌非常相似。免疫组化是诊断无色素性黑色素瘤的的重要参考。S-100及HMB-45检测阳性、角蛋白检测阴性者才能确诊[10]。本例患者标本组织病理学上瘤细胞呈圆形、椭圆形的上皮样细胞,部分瘤细胞呈胞浆空泡状的气球样细胞,排列成小片状及巢状。部分瘤细胞呈梭形,交错排列。所以病理形态上要与皮脂腺癌[11]、鳞状细胞癌[12]、
纤维肉瘤[13]相鉴别。本例标本免疫组化S -100、HMB45、Vimentin阳性,CK、EMA阴性,所以最终诊断为左眼上睑无色素性黑色素瘤。
眼睑黑色素瘤的治疗和预后取决于肿瘤的大小和有无转移。对于局限于眼睑的黑色素瘤,局部切除干净,大部分患者预后良好。Yin等[14]对64例眼睑黑色素瘤患者术后随访6个月生存率为96.5%,随访1年无转移生存率为96.05%。Harish等[15]对55例眼睑黑色素瘤患者术后随访,平均随访56个月,有6例死亡,但只有2例是由于肿瘤转移而死亡,2例是由于其它原因死亡,2例死亡原因不明。对于局部不能切除干净,或有全身转移的患者,则需要增加化疗、放疗等辅助治疗。本例患者肿瘤局限于左眼上睑,全身检查无异常,局部切除干净后随访一年余,到目前未发现有复发,说明手术效果良好。黑色素瘤是一种高度恶性的肿瘤,早期诊断、早期治疗是患者预后良好的关键因素。眼睑无色素性黑色素瘤是临床上少见的一种黑色素瘤,因其缺乏黑色素,临床表现无明显特异性,所以诊断比较困难,易与其他疾病相混淆,应引起重视。因而,对于临床上年龄较大,临床上表现为无典型霰粒肿特征的眼睑肿物患者,其手术标本均应送病理检查。
基金
1. 国 家 自 然 科 学 基 金 资 助 (30371515)。
参考文献
1. Isager P, Engholm G, Overgaard J, et al. Uveal and conjunctival malignant melanoma in denmark 1943-97: observed and relative survival of patients followed through 2002[J]. Ophthalmic Epidemiol, 2006, 13(2): 85-96.
2. Bongiorno MR, Lodato G, Affronti A, et al. Amelanotic conjunctival melanoma[J]. Cutis, 2006, 77(6): 377-381.
3. Harbour JW. Uveal and Conjunctival Melanoma: Close Together-but Only Distantly Related[J]. Oncology (Williston Park), 2016, 30(1): 44, 48.
4. Weber JL, Smalley KS, Sondak VK, et al. Conjunctival melanomas harbor BRRF and NRRS mutations--Letter[J]. Clin Cancer Res, 2013, 19(22): 6329-6330.
5. Yu GP1, Hu DN, McCormick S, et al. Conjunctival melanoma: is it increasing in the United States[J]? Am J Ophthalmol, 2003, 135(6): 800-806.
6. McLaughlin CC, Wu XC, Jemal A, et al. Incidence of noncutaneous melanomas in the U.S[J]. Cancer, 2005, 103(5): 1000-1007.
7. Huang YY, Liang WY, Tsai CC, et al. Comparison of the Clinical Characteristics and Outcome of Benign and Malignant Eyelid Tumors: An Analysis of 4521 Eyelid Tumors in a Tertiary Medical Center[J]. Biomed Res Int, 2015, 2015: 453091.
8. Abbott JJ, Amirkhan RH, Hoang MP. Malignant melanoma with a rhabdoid phenotype: histologic, immunohistochemical, and ultrastructural study of a case and review of the literature[J]. Arch Pathol Lab Med, 2004, 128(6): 686-688.
9. 叶明福, 张哉根, 王亚丽, et al. 恶性黑色素瘤组织学变异型与鉴别诊断[J]. 临床与实验病理学杂志, 2014, 20(5): 588-591.
10. Burton KK, Ashack KK, Khachemoune A. Cutaneous Squamous Cell Carcinoma: A Review of High-Risk and Metastatic Disease[J]. Am J Clin Dermatol, 2016, 17(5): 491-508.
11. Aneiros-Fernandez J, Arias-Santiago S, Espiñeira-Carmona MJ, et al. Hemangiopericytoma-like dermatofibroma with mast cells[J]. Am J Dermatopathol, 2011, 33(6):,e74-76.
12. Dasgupta T, Wilson LD, Yu JB. A retrospective review of 1349 cases of sebaceous carcinoma[J]. Cancer, 2009, 115(1): 158-165.
13. Shields CL, Kels JG, Shields JA, et al. Melanoma of the eye: revealing hidden secrets, one at a time[J]. Clin Dermatol, 2015, 33(2): 183-196.
14. Yin VT, Warneke CL, Merritt HA, et al. Number of excisions required to obtain clear surgical margins and prognostic value of AJCC T category for patients with eyelid melanoma[J]. Br J Ophthalmol, 2014, 98(12): 1681-1685.
15. Harish V, Bond JS, Scolyer RR, et al. Margins of excision and prognostic factors for cutaneous eyelid melanomas[J]. J Plast Reconstr Aesthet Surg, 2013, 66(8): 1066-1073.